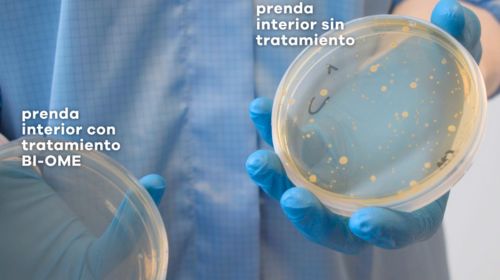

Alsico ha lanzado una nueva línea de vestuario interior para salas blancas fabricada con el tejido Alsisandwash con tecnología BI-OME®, que garantiza una frescura e higiene óptimas para los entornos más exigentes. Esta tecnología antimicrobiana no solo elimina microorganismos, sino que también reduce la actividad de los virus, ofreciendo un nivel de protección integral y sostenible sin afectar a las personas ni al medio ambiente.
A diferencia de los tratamientos antimicrobianos tradicionales, como los basados en iones de plata, BI-OME® mantiene su eficacia durante todo el ciclo de vida de las prendas, gracias a su fijación en la superficie del tejido.
Ventajas clave de BI-OME®:
- Reduce el bioburden en salas blancas.
- Facilita una correcta técnica de gowning aséptico.
- Controla olores y elimina manchas causadas por microorganismos.
- Es hipoalergénico y seguro para el medio ambiente.
- Mantiene su eficacia antimicrobiana tras múltiples lavados.
- Ofrece máximo confort al usuario.
- No contiene metales ni plata, y su tecnología es biodegradable.
¿Cómo funciona BI-OME®?
Esta tecnología aprovecha un revestimiento de carga positiva en el tejido, que atrae a los microbios debido a sus membranas celulares de carga negativa. Este mecanismo actúa contra una amplia gama de microorganismos, incluidos bacterias y virus, perforando sus membranas y desactivándolos para evitar su proliferación.
Durabilidad comprobada:
A diferencia de otras soluciones, BI-OME® no requiere reaplicación, ya que su acción antimicrobiana es permanente y resiste incluso múltiples ciclos de lavado.
Más allá de lo antibacteriano:
BI-OME® ofrece una acción antimicrobiana de amplio espectro, lo que significa que no solo actúa contra bacterias, sino también contra virus y otros microorganismos pirógenos, posicionándose como una solución integral para entornos críticos como las salas blancas.
Para más información sobre esta innovadora tecnología y sus aplicaciones, visita el sitio web oficial: vestilab.com/es/categorias/bi-ome.